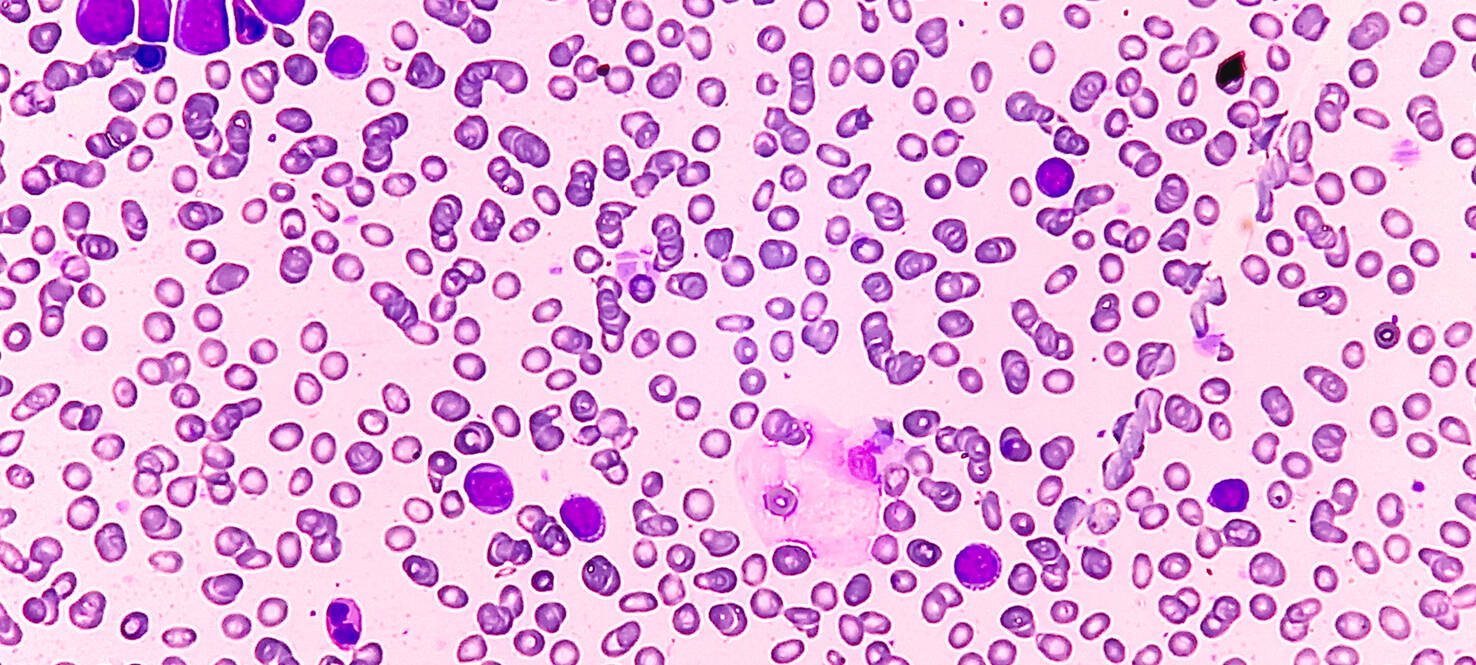

Using Machine Learning To Predict Response in Acute Myeloid Leukemia
Onyee Chan, MD, an oncologist at Moffitt Cancer Center specializing in malignant hematology, is analyzing how machine learning using a type of probabilistic graphical model can be used to predict response in patients diagnosed with acute myeloid leukemia (AML).
AML is a cancer that affects the blood and bone marrow. Although it is relatively rare overall, it’s one of the most common types of leukemia found in adults.
“Traditional AML risk-stratification systems, including the widely used European LeukemiaNet (ELN) classification, offer broad prognostic categories yet fall short in generating individualized, patient-level predictions,” Chan explained.
Bayesian Model Advantage
In this study, Chan and the research team examined 55 distinct clinical and pathologic variables per patient across a cohort of more than 600 acute myeloid leukemia patients identified from Moffitt’s database between 2011 and 2023.

According to Chan, an important advantage of the Bayesian graphical model approach is that probabilities can be revised when new information becomes available, allowing integration of the latest evidence and expert knowledge. The model could help to develop an individualized treatment plan and identify which patients are at high risk of frontline treatment failure.
“For example, using this model, we can enter details such as a patient’s mutation profile, treatment history or past cancers, and the system will generate the outcome probability,” Chan said.
“I would be able to sit in the clinic with a patient and click through their specific characteristics, and in real time, see what the percentage is of reaching remission with a particular chemotherapy regimen, intensive or nonintensive chemotherapy. Because the model is a form of explainable artificial intelligence, it also displays the relationships between variables making the reasoning behind its predictions fully visible.”
Continuing Research
Overall, Chan says the pilot study demonstrates the model’s potential to strategically advance clinical decision-making for frontline treatment of acute myeloid leukemia. Moving forward, the team plans to expand the cohort, integrate additional treatment regimens (both frontline and subsequent lines) into the platform, and collaborate with other cancer centers to crossvalidate the tool and strengthen its predictive power.